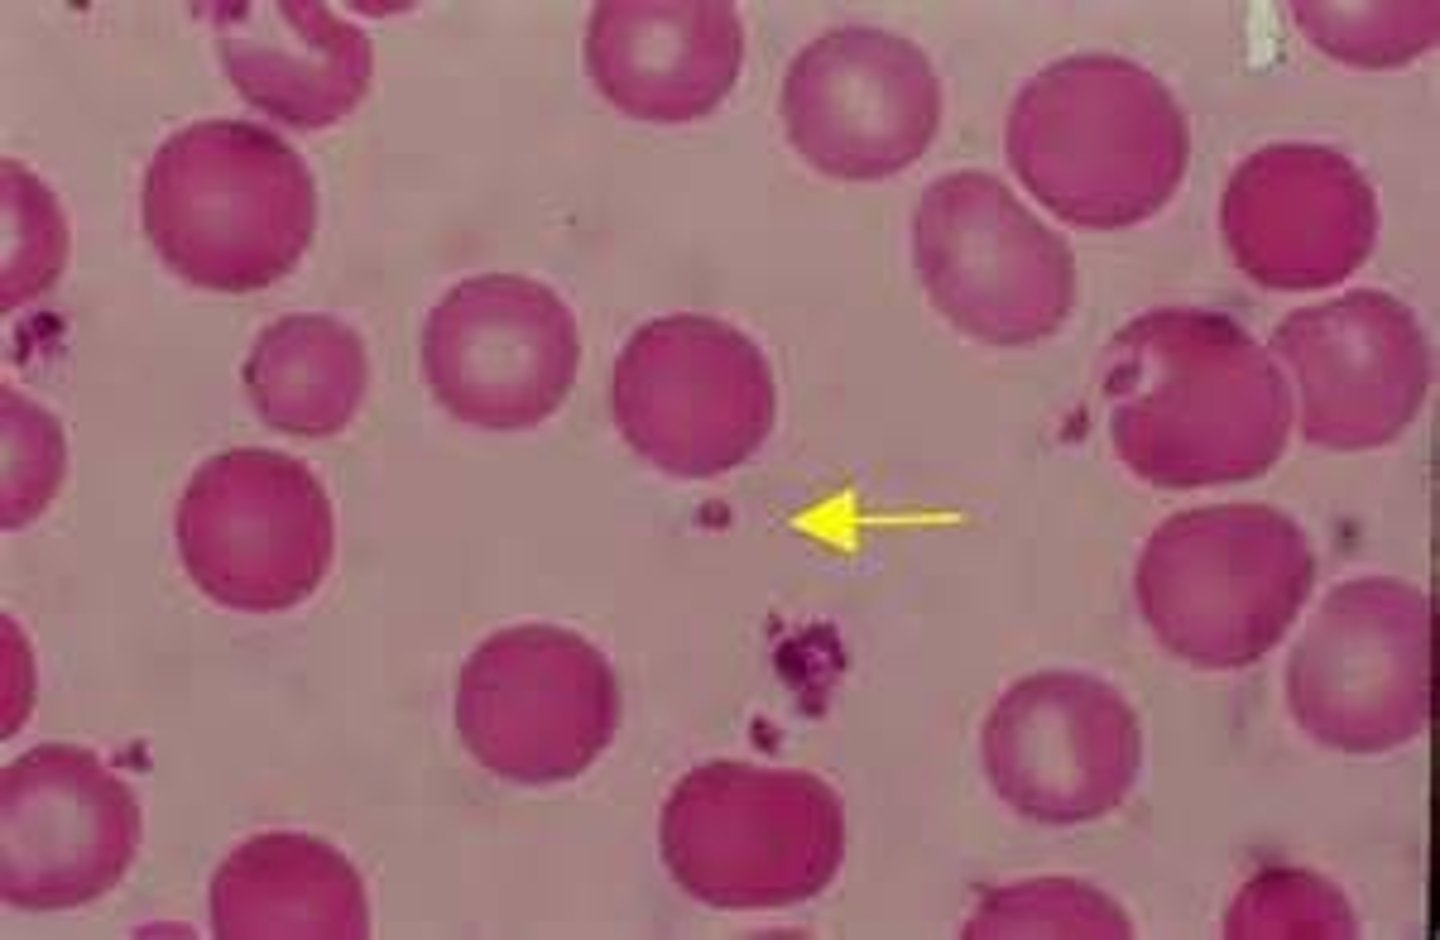
knowt flashcard image
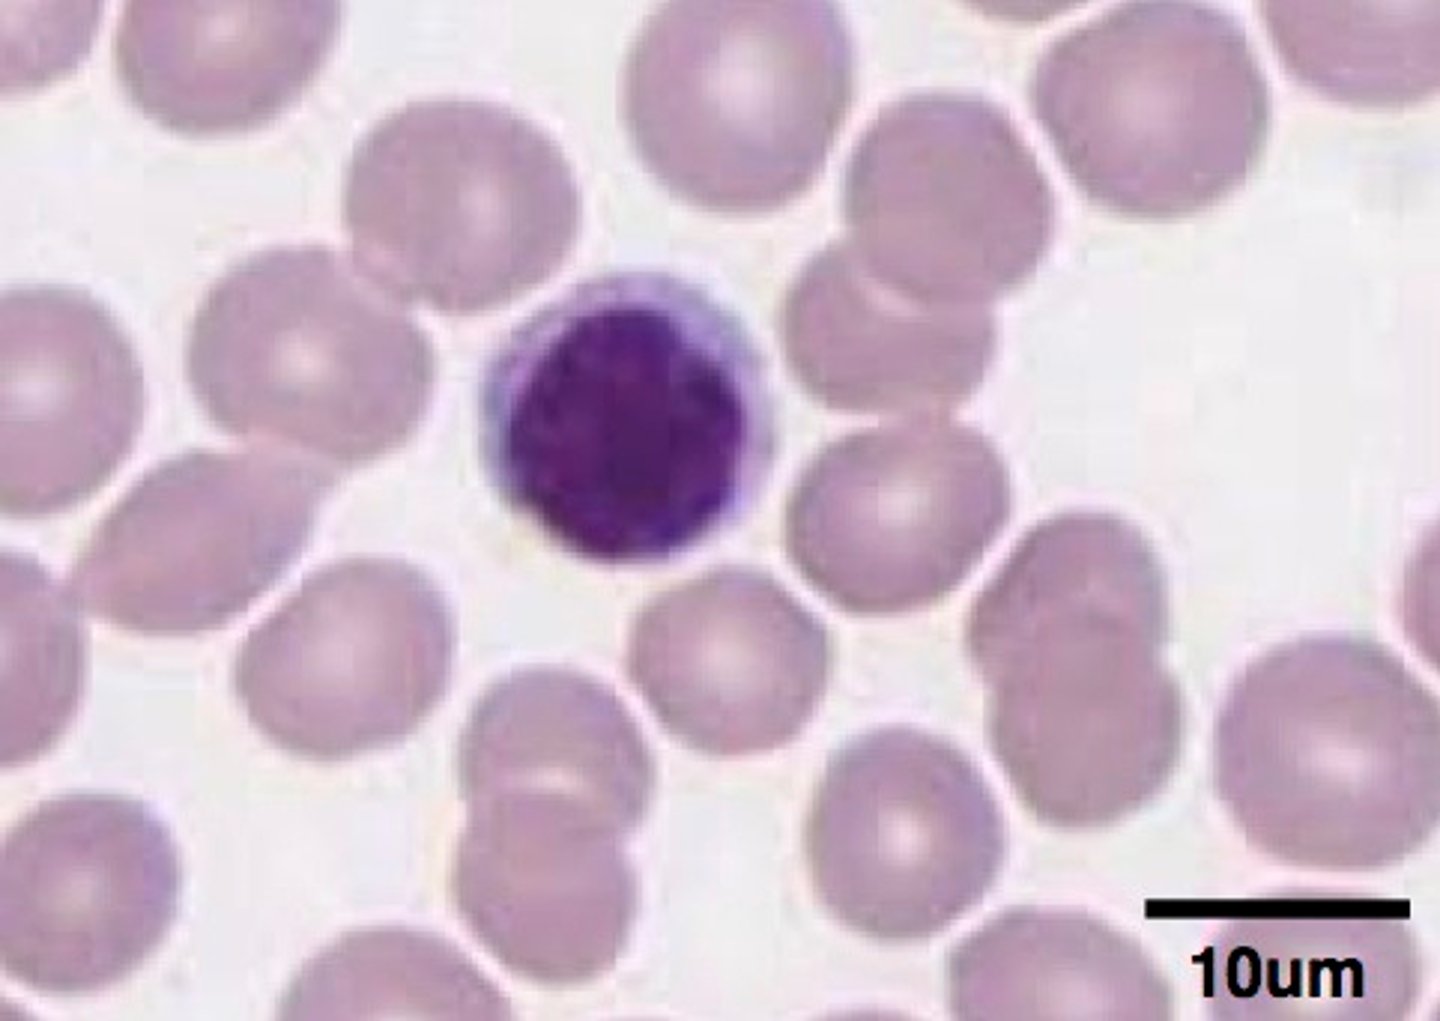
<p>what is the name of this leukocyte, and is it a granulocyte? what is its function?</p>

1/185
Looks like no tags are added yet.
Name | Mastery | Learn | Test | Matching | Spaced | Call with Kai |
|---|
No analytics yet
Send a link to your students to track their progress
thyroid gland
what organ does this slide show

parathyroid gland
what organ does this slide show

follicular cells of thyroid gland
1

colloid filled follicles of thyroid gland

chief cells of parathyroid gland

anterior pituitary gland
1

posterior pituitary gland
2

acidophils of anterior pituitary
B

basophils of anterior pituitary
A

pituicytes of posterior pituitary
2

pituitary gland (hypophysis)
what organ is this

adrenal gland (suprarenal gland)
what organ is this

capsule of adrenal gland
1

zona glomerulosa of adrenal gland
2

zona fasciculata of adrenal gland
3

zona reticularis of adrenal gland
4

adrenal medulla of adrenal gland
5

pancreas
what organ is this slide from

pancreatic islets of langerhans of pancreas
2

pancreatic acini (exocrine cells) of pancreas
1

alpha cells of pancreas (produce glucagon)

beta cells of pancreas (produce insulin)

thyroid hormone
a key component in temperature regulation. Without this hormone, the body must rely more on shivering for temperature regulation. This requires more oxygen consumption for ATP generation.
thyroid gland

thymus gland

pericardium

nares

larynx

glottis

trachea

epiglottis

esophagus

stomach

pancreas

caudate lobe

quadrate lobe

spleen

epididymis

ductus deferens (vas deferens)

uterine body
C

uterine horns

uterine tube (oviduct)

ovary

uterus

erythrocytes

platelets (thrombocytes)
neutrophil; yes; bacterial and fungal infection
what is the name of this leukocyte, and is it a granulocyte? what does it fight against?

B-cells lymphocyte; no; produce antibodies to fight bacteria, viruses, and toxins
what is the name of this leukocyte, and is it a granulocyte? what is its function?

eosinophil; yes; parasitic infections and allergic reactions
what is the name of this leukocyte, and is it a granulocyte? what does it fight against?

T-cell lymphocyte; no; regulate antigens and can kill other cells
what is the name of this leukocyte, and is it a granulocyte? what is its function?
monocyte; no; phagocytosis of pathogens
what is the name of this leukocyte, and is it a granulocyte? what is its function?

basophil; yes; allergic and antigen response
what is the name of this leukocyte, and is it a granulocyte? what is its function?

blood type A+
Has A and Rh antigens
Has Anti-B
blood type AB-
A and B antigens
no antibodies
blood type O+
Rh antigens
Anti-A and Anti-B
blood type O-
universal donor
intercalated discs

obstructive pulmonary disease
increased airway resistance (e.g., bronchitis)
TLC, FRC, RV may increase; FEV1/FVC ratio decreases, decreased FEV1
restrictive pulmonary disease
PFT may show ↑ FEV1/FVC.; FEV1, FVC, and TLC reduced
kussmaul breathing
lung volumes and (F)VC decreased
thyroid cartilage

cricoid cartilage

arytenoid cartilage

IRV

ERV

TV

RV

TLC

FRC

VC

IC

amylase
mouth releases salivary _________________ that starts chemical digestion of carbohydrates
peristalsis
Involuntary waves of muscle contraction that keep food moving along in one direction through the digestive system
pepsin
________________ released to start chemical digestion of protein into larger peptides. released in stomach
segmentation
mixes the contents of the tract with intestinal secretions, brings chyme into contact with absorptive epithelium, happens in the small intestine
pancreas
releases "pancreatic juice", neutralizes the chyme and releases enzymes for chemical digestion
liver
makes bile, which is stored in the gallbladder. both release bile into the small intestine to emulsify the lipids in the chyme
starch/disaccharides
digestion continues with pancreatic amylase
protein
digestion continues with pancreatic proteases like trypsin
lipid (fat)
almost all __________________ digestion with pancreatic lipase after bile salt emulsification
brush border enzymes
finish up breaking down all the nutrients digestion
protein digestion
begins in the stomach
carbohydrate digestion
starts in the mouth with amylase converting polysaccharides to disaccharides, continues with pancreatic amylase, finishes with sucrase/maltase/lactase from the small intestine converting disaccharides to monosaccharides (glucose/fructose/galactose)
lipid digestion
[digestion] when chyme is present, the duodenum secretes cck (cholecystokinin) hormone into the blood, which stimulates the secretion of pancreatic enzymes and bile and promotes satiety; bile made in the liver emulsifies fat in the small intestine but isn't an enzyme; lipase is an enzyme made in the pancreas that hydrolyzes lipids (also in the small intestine)
chewing
mechanical digestion of mouth
receptive relaxation
reflex-mediated relaxation of smooth muscle coordinated by swallowing center of brain stem
amylase
Enzyme in saliva that breaks the chemical bonds in starches
protease
enzyme that digests protein
trypsin
an enzyme from the pancreas that digests proteins in the small intestine
lipase
pancreatic enzyme necessary to digest fats
seminiferous tubule of testis

interstitial cells of leydig of testis

sperm cells of testis

pseudostratified columnar epithelium of epididymis

stereocilia of epididymis

sperm mass cells of epididymis

Graafian (vesicular) follicle of ovary

antrum of graafian follicle of ovary
blue

corona radiata
C

zone pellucida
E
